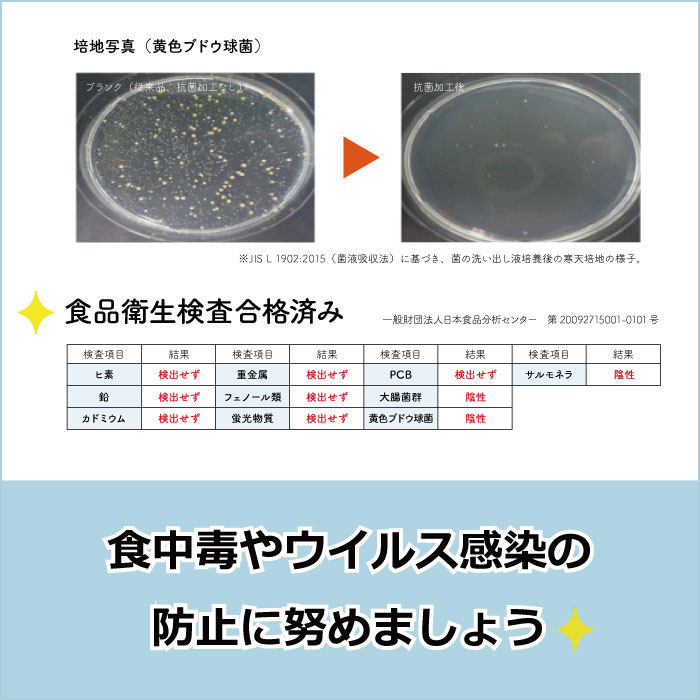
業務用 抗菌 ペーパータオル 220×230mm ダブル 200組(400枚) 30パック ソフトタイプ 50200024

抗菌ペーパータオル 220×230mm ダブル 200組(400枚) 30パック ソフトタイプ 50200024
商品コード:50200024
¥5,148 (税込)
商品説明
- 製造元
- イトマン株式会社
- 配送情報
- 決済完了後4営業日以内に出荷(休業日除く)
ソフトタイプ2枚重ねやわらかさNo.1!まるでティシュのような、ソフトなさわり心地です。 手にもやさしく、柔らかいのでゴミの量を大幅に軽減できます。 |
安心の無漂白&蛍光剤不使用!イトマンの製品は全て再生紙100%で出来ています。 漂白剤や蛍光剤は一切使用していません。そのため、わずかに紙のインクが黒い点となって残っている場合がありますが、人体に影響はございません。 安心してご使用ください。 |
衛生的で便利不特定多数が使うタオルや菌が飛散する恐れのあるエアー式タオルと違い、使い捨て商品なので、とても衛生的です。 |
| 商品詳細 | |
|---|---|
| 商品番号 | 50200008 |
| 仕様規格 | ソフト ダブル 再生紙100% 400枚(200組) 紙サイズ:220×230mm |
| 入数 | 30個 |
| 商品サイズ | ・単品サイズ(mm) 220×120×80mm 約308g ・ダンボールサイズ(mm) 630×225×445mm 約9.9kg |
| その他 | 領収書、納品書等の書類は同梱されておりません。 ご希望の際は、発送についてのご案内メールに記載されておりますURLにアクセスいただきお客様ご自身で発行をお願い致します。 |
商品詳細

お客様のレビュー(0)
レビューはまだありません

カレンダー
カレンダー